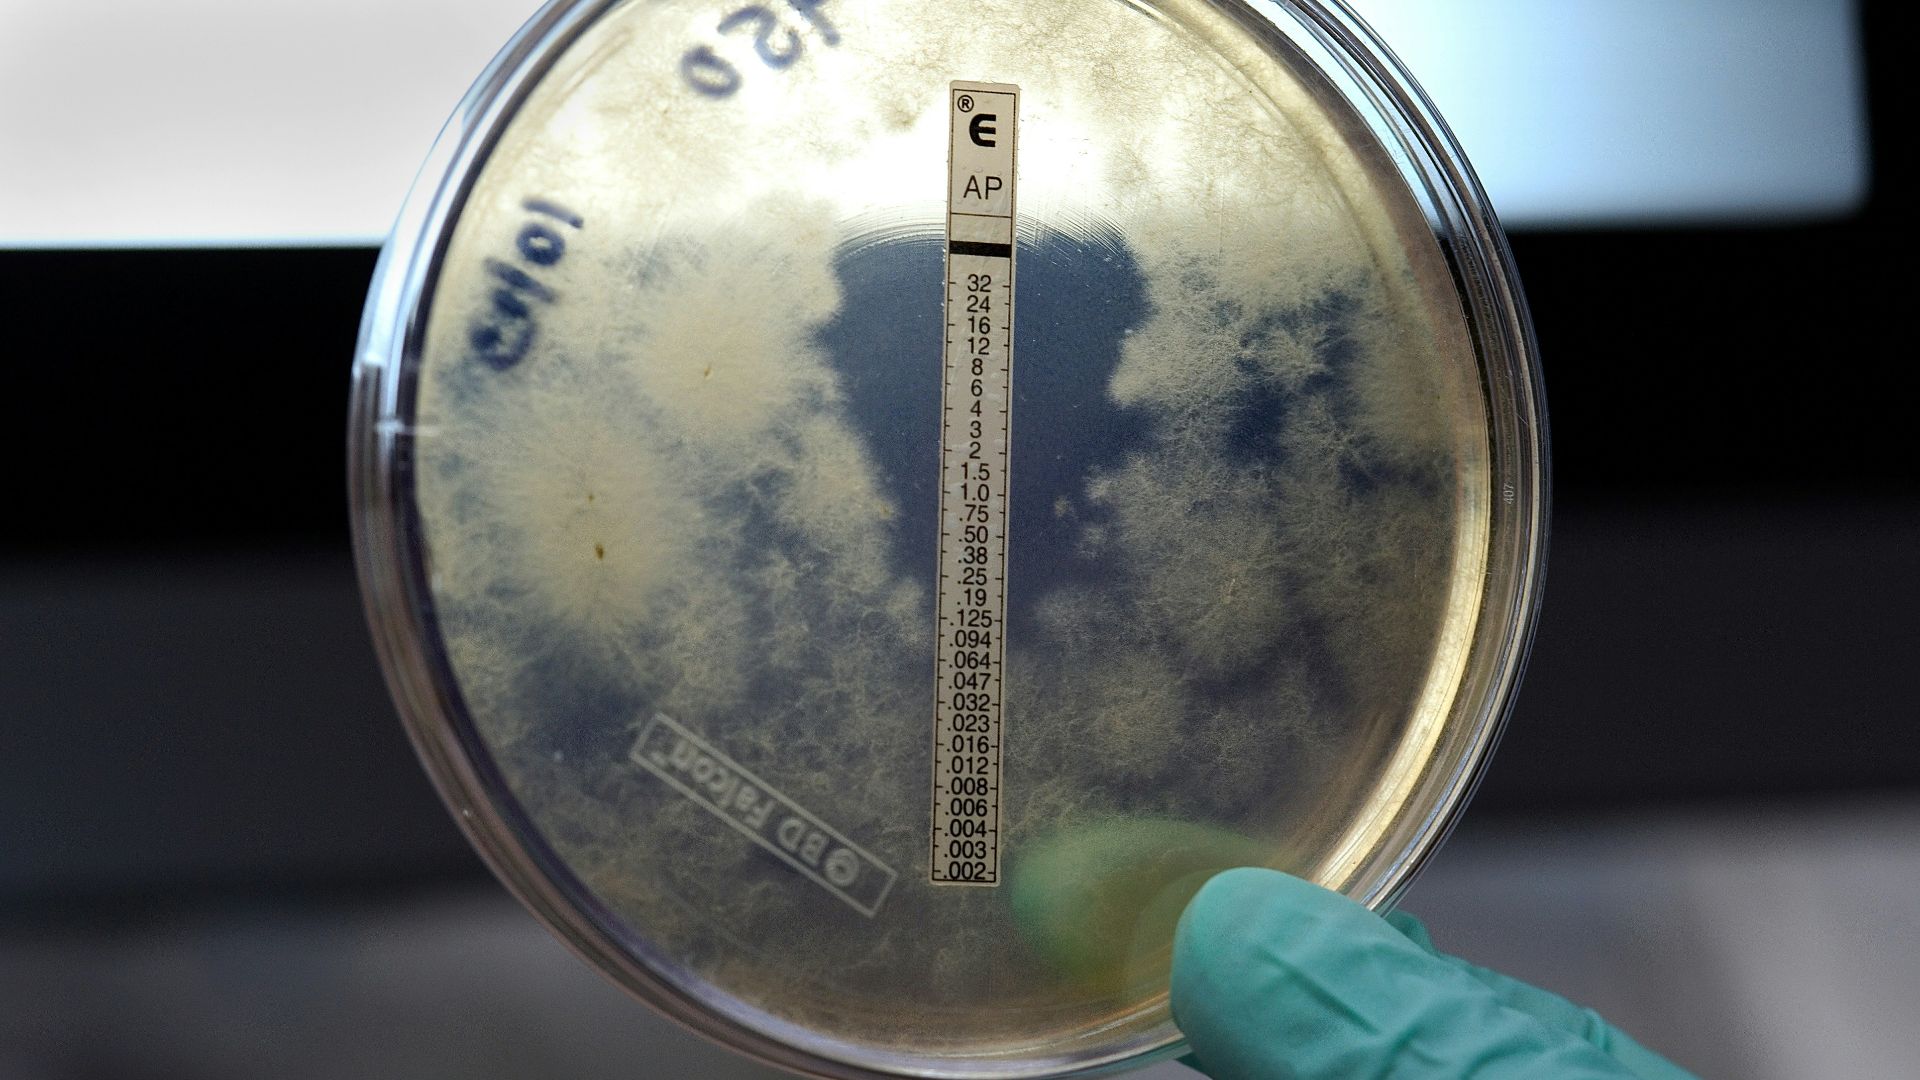
11. Neisseria Meningitidis

Les bactéries peuvent vivre là où personne ne veut d’elles, survivre sur des surfaces que les gens jurent avoir nettoyées et évoluer autour des médicaments qui semblaient autrefois être la solution définitive. Les scientifiques ne s’effraient pas facilement, mais certaines bactéries ont gagné un respect particulier, celui qui change la façon dont les laboratoires sont construits, dont les hôpitaux fonctionnent et dont les agences de santé publique communiquent avec le public. Certains de ces microbes sont devenus tristement célèbres à la suite de pandémies historiques ; d’autres ont pris le pouvoir dans les services hospitaliers modernes, se cachant à la vue de tous parmi les ventilateurs et les perfusions. Voici vingt poids lourds bactériens qui ont attiré l’attention des chercheurs, des cliniciens et des épidémiologistes de la manière la plus inconfortable qui soit.
1. Bacillus Anthracis

L’anthrax a un sombre passé qui comprend des épidémies chez le bétail, des infections mortelles chez l’homme et une longue histoire dans la planification de la biodéfense, y compris les discussions de la « catégorie A » du CDC. Ses spores peuvent persister dans l’environnement, ce qui fait que le problème ressemble moins à un seul patient malade qu’à un paysage qui doit être respecté.
2. Yersinia Pestis

Il s’agit de la bactérie responsable de la peste, liée à des pandémies historiques comme la peste noire dans l’Europe médiévale, et qui est encore présente aujourd’hui dans certaines régions du monde. Les scientifiques la prennent au sérieux car elle peut se propager rapidement, frapper fort et rappeler à tous que l’histoire n’est pas toujours terminée.
3. Vibrio Cholerae

Le choléra est une catastrophe d’origine hydrique qui survient lorsque les systèmes d’assainissement s’effondrent. Des épidémies ont été documentées dans des contextes allant des villes du XIXe siècle aux crises humanitaires modernes. Il terrifie par sa rapidité et son ampleur, en particulier lorsque l’eau potable se fait rare et que les règles élémentaires de la vie quotidienne s’effondrent.
4. Mycobacterium tuberculosis

La tuberculose accompagne l’humanité depuis des siècles, et l’inquiétude s’est accentuée avec l’émergence et la propagation de souches résistantes aux médicaments. Il s’agit d’une menace à combustion lente, qui peut rester latente dans une communauté, puis surgir lorsque l’accès aux soins de santé se détériore.
5. Mycobacterium Leprae

La lèpre porte une ombre culturelle démesurée, mais le malaise scientifique vient de ses lésions nerveuses et de sa longue incubation furtive. La médecine moderne peut la traiter, mais l’histoire de cette bactérie montre à quel point une infection peut façonner les sociétés, et pas seulement les corps.
6. Clostridium Botulinum

Le botulisme ressemble à une histoire d’horreur écrite par un inspecteur de la sécurité alimentaire. La toxine peut provoquer une paralysie, et les cas liés à des aliments mal conservés ou à des produits contaminés ont maintenu les laboratoires de santé publique en alerte pendant des générations.
7. Clostridium Tetani

Le tétanos nous rappelle qu’une petite blessure peut devenir quelque chose de bien plus grave si les conditions sont réunies. Les scientifiques respectent la puissance de sa toxine et savent à quel point la maladie peut être impitoyable sans prévention.
8. Clostridioides difficile

Le C. diff prospère dans la réalité chaotique des soins de santé, où les antibiotiques perturbent la flore intestinale normale et où des spores résistantes persistent sur les surfaces. C’est le type d’infection qui peut transformer un séjour hospitalier de routine en une deuxième bataille épuisante, c’est pourquoi les équipes de contrôle des infections la traitent comme un incendie domestique.
9. Staphylococcus Aureus

Le staphylocoque a toujours été un problème, et l’émergence du SARM a donné l’impression que le sol se dérobait sous les pieds de la médecine. Les chercheurs le surveillent de près, car il peut passer d’un problème cutané mineur à une infection potentiellement mortelle, en particulier lorsque la résistance limite les moyens d’action habituels.
10. Streptococcus Pyogenes

Le streptocoque du groupe A est le méchant bien connu derrière l’angine streptococcique, mais il a aussi un côté plus sombre, notamment des infections invasives qui peuvent s’aggraver rapidement. Le facteur de peur vient de la rapidité avec laquelle il peut transformer des symptômes ordinaires en une urgence médicale qui n’attend pas.
11. Neisseria Meningitidis
La méningococcie est le type de maladie qui fait parler plus vite les cliniciens et taire les familles. Elle peut provoquer des méningites et des infections sanguines, et des épidémies dans des environnements confinés comme les dortoirs ont montré comment une bactérie peut exploiter la proximité humaine.
12. Salmonella Enterica Serovar Typhi

La fièvre typhoïde a façonné les campagnes militaires et les réformes de santé publique, et elle reste une préoccupation majeure là où l’eau potable et l’assainissement ne sont pas fiables. Les scientifiques font encore référence à l’époque de « Typhoid Mary » car elle illustrait quelque chose de troublant : des personnes en bonne santé peuvent propager discrètement des maladies graves.
13. Shigella Dysenteriae

Shigella se propage avec une efficacité redoutable, en particulier là où l’hygiène est difficile à maintenir, et elle est depuis longtemps à l’origine d’épidémies de dysenterie. Elle inquiète les chercheurs car elle peut toucher rapidement les populations vulnérables, et la résistance aux antibiotiques a compliqué les efforts de contrôle dans certaines régions.
14. Escherichia Coli O157:H7

La plupart des E. coli sont des voisins inoffensifs dans l’intestin, mais O157:H7 est le tristement célèbre cas particulier lié à de graves épidémies d’origine alimentaire, notamment l’incident Jack in the Box de 1993, dont tout le monde se souvient. Il est terrifiant car la voie d’exposition peut être ordinaire, comme du bœuf mal cuit ou des produits contaminés, et les conséquences peuvent être tout sauf ordinaires.
15. Listeria Monocytogenes

La Listeria est redoutée pour sa capacité à envahir la circulation sanguine et le système nerveux central, et pour la façon dont elle cible les femmes enceintes, les nouveau-nés et les personnes âgées. Les épidémies liées aux aliments prêts à consommer, notamment celle bien documentée de 2011 aux États-Unis concernant les cantaloups, qui a fait l’objet d’une enquête des autorités de santé publique, ont donné l’impression que le danger pouvait se cacher dans le réfrigérateur.
16. Francisella Tularensis

La tularémie a acquis la réputation d’être hautement infectieuse dans certaines conditions, et c’est pour cette raison qu’elle apparaît dans les discussions du CDC sur la biodéfense. Les chercheurs y prêtent attention car une seule voie d’exposition peut suffire à provoquer une maladie grave, et la bactérie a le don d’apparaître par le biais du contact avec la faune sauvage et l’extérieur.
17. Espèces Brucella

La brucellose est une leçon sur le lien étroit entre la santé humaine et les animaux et les systèmes alimentaires, souvent associée à la consommation de produits laitiers non pasteurisés ou à l’exposition au bétail. Elle peut provoquer une maladie longue et épuisante qui persiste, ce qui en fait un adversaire tenace plutôt qu’un sujet d’actualité éphémère.
18. Burkholderia Pseudomallei

C’est la cause de la mélioïdose, une maladie longtemps associée aux sols tropicaux et aux fortes pluies, en particulier dans certaines régions d’Asie du Sud-Est et du nord de l’Australie. Les scientifiques s’inquiètent car elle peut imiter d’autres maladies, récidiver après une apparente amélioration et nécessite des diagnostics minutieux auxquels toutes les cliniques n’ont pas facilement accès.
19. Pseudomonas Aeruginosa

Pseudomonas se développe dans les environnements humides et adore l’écosystème hospitalier moderne, des lavabos aux équipements respiratoires. Il est connu pour sa résistance et pour exploiter les systèmes immunitaires affaiblis, c’est pourquoi il apparaît souvent dans les conversations sérieuses sur les infections associées aux soins de santé.
20. Acinetobacter Baumannii

Acinetobacter est devenu le symbole des infections hospitalières difficiles à traiter, en particulier dans les unités de soins intensifs où les patients vulnérables ont peu de marge d’erreur. Les chercheurs le surveillent de près, car il peut survivre sur les surfaces, résister à plusieurs antibiotiques et transformer le contrôle routinier des infections en une tâche constante et méticuleuse.